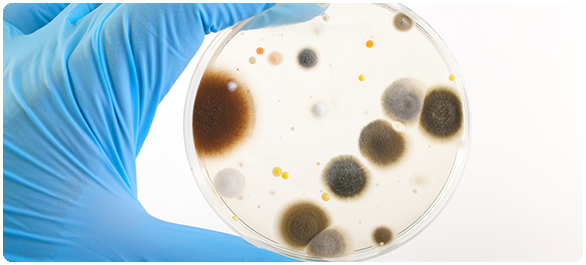
เชื้อรา เชื้อรา

on
เชื้อรา (Fungal infection)
เชื้อรา (Fungus) คือจุลชีพ (Microorganism ได้แก่ แบคทีเรีย ไวรัส เชื้อรา และปรสิต) ชนิดหนึ่งที่สามารถก่อโรคได้ โดยโรคที่เกิดจากเชื้อราเรียกว่า โรคเชื้อรา (Mycosis หรือ Fungal infection)
โดยทั่วไปเชื้อราหลากหลายชนิดอาศัยอยู่ในร่างกายเราเช่น ในช่องปาก ในช่องคลอด และในลำไส้ใหญ่ โดยอยู่ร่วมกันอย่างมีสมดุลกับแบคทีเรียและจะไม่ก่อโรคเมื่อสมดุลนั้นคงอยู่ร่วมกับร่างกายเราแข็งแรง
เชื้อราติดต่อกันได้ระหว่างคน จากการสัมผัสทางบาดแผลและทางการหายใจ ดังนั้นในระยะแรกของการติดเชื้อราจึงมักเป็นโรคที่เกิดกับผิวหนังหรือปอด แต่ถ้าโรครุนแรง เชื้อราสามารถแพร่เป็นการติดเชื้อทางกระแสโลหิต (ภาวะพิษเหตุติดเชื้อ) ไปยังทุกเนื้อเยื่อ/อวัยวะของร่างกาย เช่น สมอง ตับ ไต
ผู้มีปัจจัยเสี่ยงต่อการเกิดโรคเชื้อราคือ ขาดสุขอนามัยพื้นฐาน (สุขบัญญัติแห่งชาติ) รักษาความสะอาดผิวหนังไม่เพียงพอ ผิวหนังเปียกชื้นเสมอ ชอบใช้ของใช้ร่วมกับผู้อื่น กินยาปฏิชีวนะพร่ำเพรื่อ (เพราะจะเปลี่ยนสมดุลระหว่างเชื้อแบคทีเรียและเชื้อรา เชื้อราจึงเจริญผิดปกติจนก่อโรคได้) กิน/ใช้ยาที่กดภูมิคุ้มกันต้านทานโรค ( เช่น ยาในกลุ่มสเตียรอยด์ ยาเคมีบำบัด) เป็นโรค เบาหวาน เป็นโรคที่ส่งผลให้มีภูมิคุ้มกันต้านทานโรคบกพร่อง (เช่น การติดเชื้อเอชไอวีหรือโรคเอดส์)
อาการของเชื้อราจะเช่นเดียวกับอาการติดเชื้อแบคทีเรียหรือไวรัสเช่น
- มีผื่น แผล คัน บวม แดง ถ้าเกิดที่ผิวหนังเช่น โรคกลาก เกลื้อน โรคน้ำกัดเท้า
- หรือก่ออาการอักเสบ บวม เป็นก้อน ฝี หนอง เมื่อเกิดในเนื้อเยื่อ/อวัยวะต่างๆเช่น โรคเชื้อราใน ช่องคลอด ปอดอักเสบจากเชื้อรา สมองอักเสบจากเชื้อรา เป็นต้น
แพทย์วินิจฉัยโรคเชื้อราได้ด้วยวิธีเดียวกับโรคจากการติดเชื้อต่างๆคือ จากประวิติอาการ ประวัติการใช้ยาต่างๆ การตรวจร่างกาย และอาจขูดเอาเซลล์ในตำแหน่งรอยโรคเพื่อการตรวจด้วยกล้องจุลทรรศน์หรือเพื่อการเพาะเชื้อ หรือการตัดชิ้นเนื้อในตำแหน่งเกิดโรคเพื่อการตรวจทางพยาธิวิทยา
การรักษาโรคเชื้อราคือ การทายา สอดยา กินยา หรือฉีดยา ต้านเชื้อรา ซึ่งจะใช้วิธีการใดขึ้นกับตำแหน่งที่เกิดโรคและความรุนแรงของโรค
การป้องกันการติดเชื้อราคือ การรักษาสุขอนามัยพื้นฐาน (สุขบัญญัติแห่งชาติ) การรักษาผิวหนังให้แห้งและสะอาดเสมอ การไม่ใช่ของใช้ร่วมกับผู้อื่นเช่น เสื้อผ้า ถุงเท้า รองเท้า หวี และการใช้ถุงยางอนามัยชายเมื่อมีเพศสัมพันธ์ เพราะเชื้อราบางชนิดเป็นโรคติดต่อทางเพศสัมพันธ์ได้เช่น โรคเชื้อราในช่องคลอด
บรรณานุกรม
- Fungal infections [2015,Sept12]
- Fungus [2015,Sept12]
- Mycosis [2015,Sept12]
Updated 2015, Sept 12